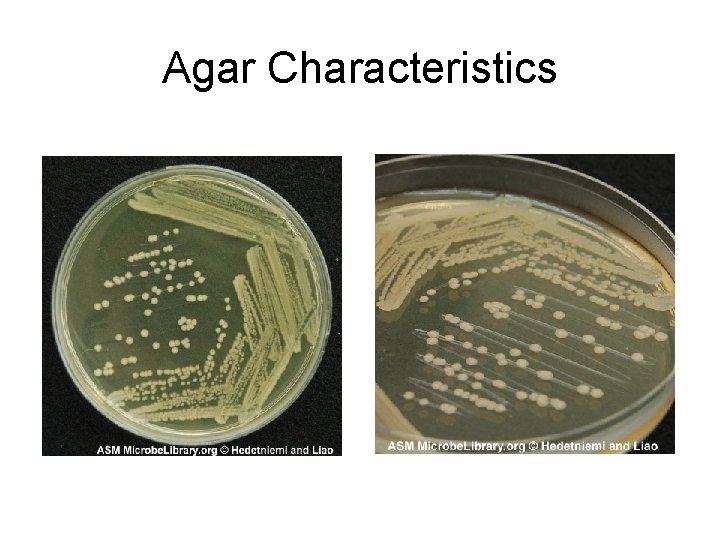
Agar Characteristics
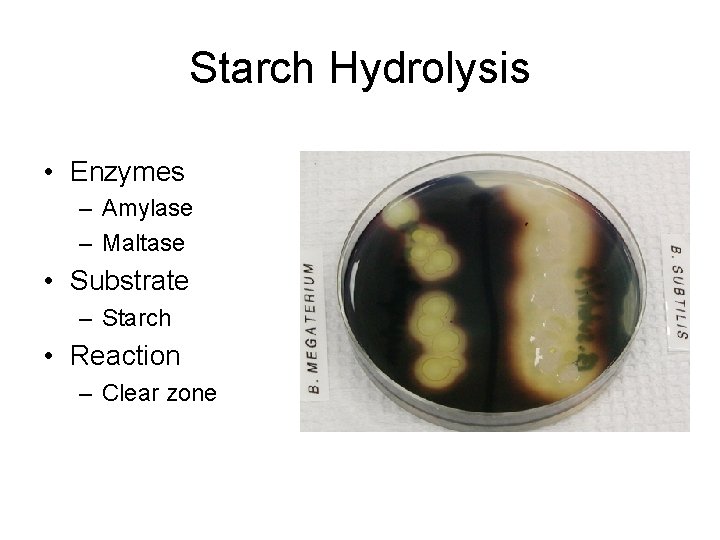
Starch Hydrolysis • Enzymes – Amylase – Maltase • Substrate – Starch • Reaction
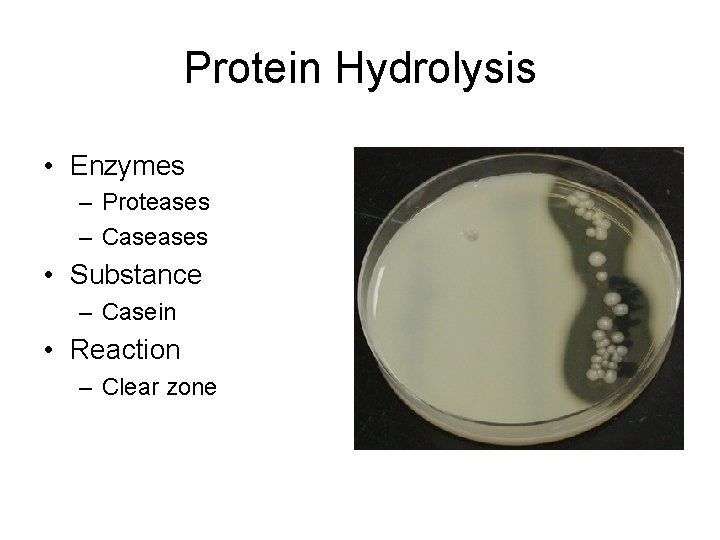
Protein Hydrolysis • Enzymes – Proteases – Caseases • Substance – Casein • Reaction
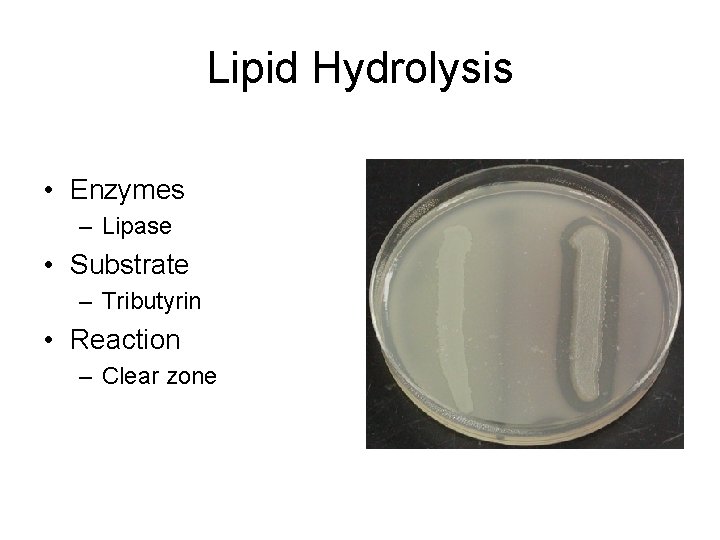
Lipid Hydrolysis • Enzymes – Lipase • Substrate – Tributyrin • Reaction – Clear
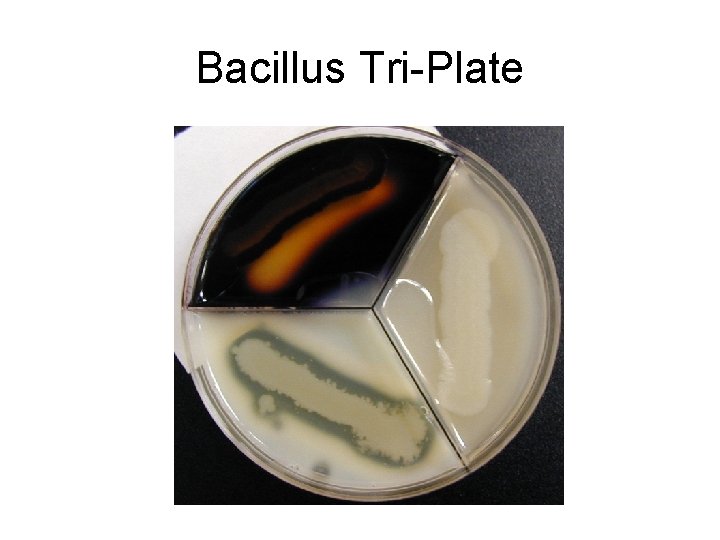
Bacillus Tri-Plate
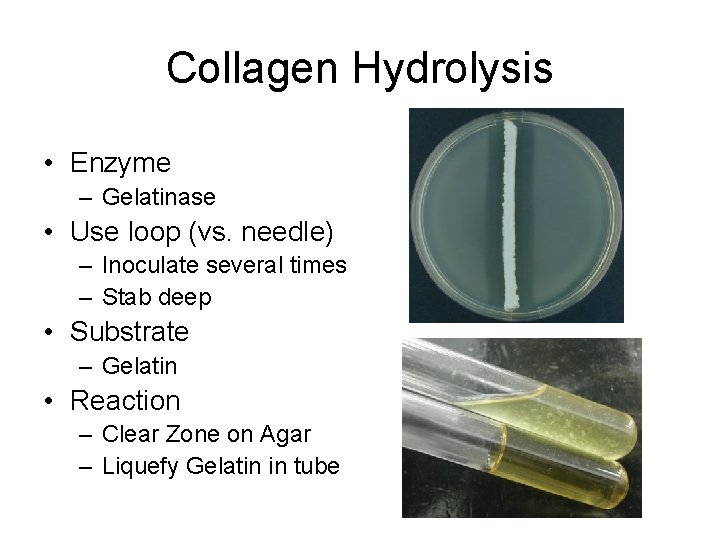
Collagen Hydrolysis • Enzyme – Gelatinase • Use loop (vs. needle) – Inoculate several
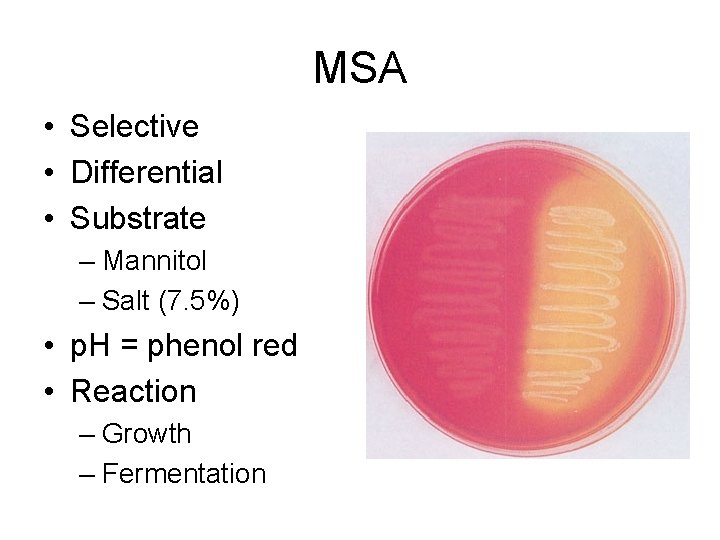
MSA • Selective • Differential • Substrate – Mannitol – Salt (7. 5%) •
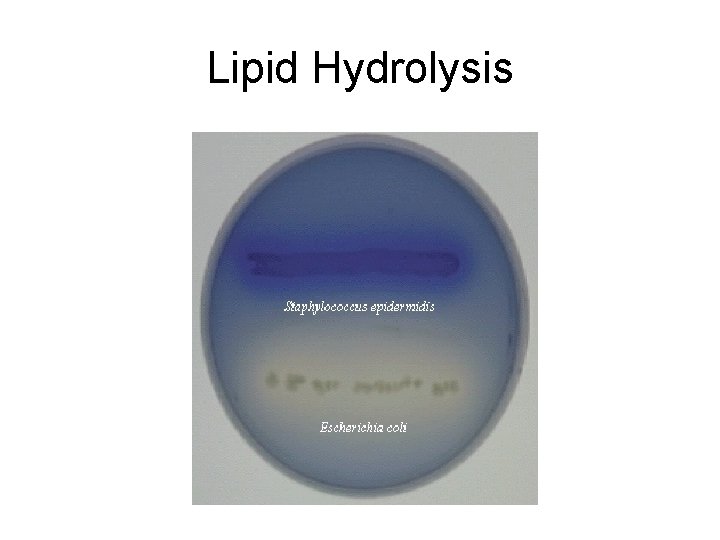
Lipid Hydrolysis
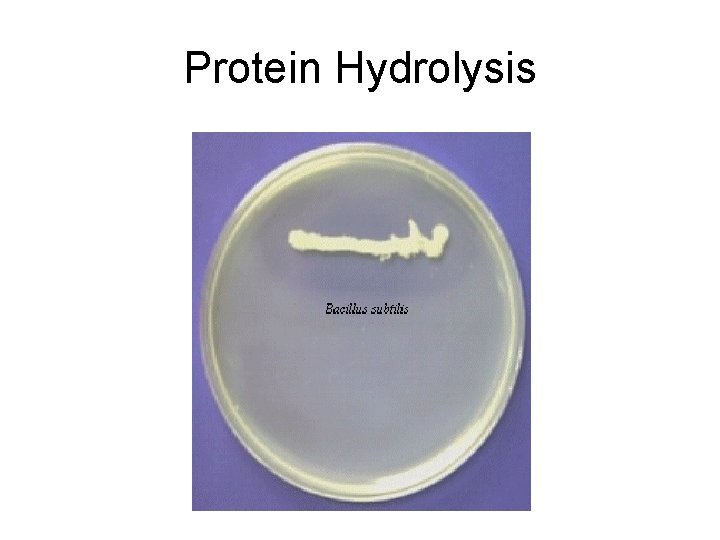
Protein Hydrolysis
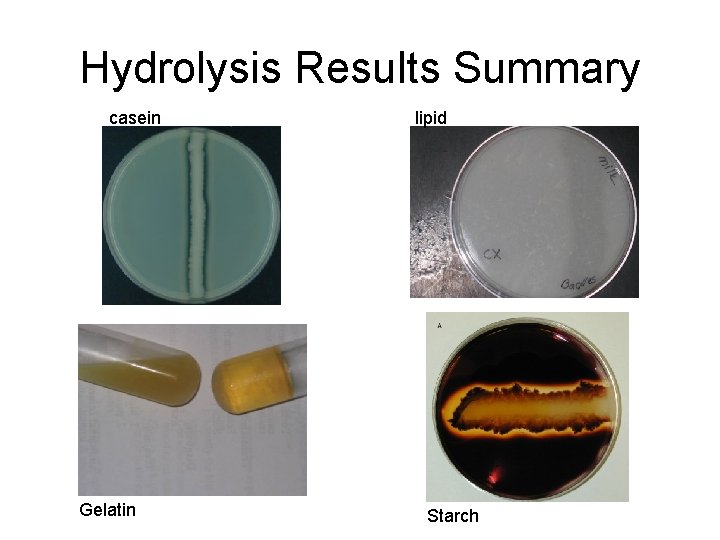
Hydrolysis Results Summary casein Gelatin lipid Starch

Bacillus Bacillus sp GP rod Spore former Examples

Bacillus

Bacillus sp. • GP rod • Spore former • Examples – – B. anthracis B. cereus B. subtilis B. megatarium • Exoenzymes – – Lipase Amylase Casease Gelatinase

Spores
Agar Characteristics
Starch Hydrolysis • Enzymes – Amylase – Maltase • Substrate – Starch • Reaction – Clear zone
Protein Hydrolysis • Enzymes – Proteases – Caseases • Substance – Casein • Reaction – Clear zone
Lipid Hydrolysis • Enzymes – Lipase • Substrate – Tributyrin • Reaction – Clear zone
Bacillus Tri-Plate
Collagen Hydrolysis • Enzyme – Gelatinase • Use loop (vs. needle) – Inoculate several times – Stab deep • Substrate – Gelatin • Reaction – Clear Zone on Agar – Liquefy Gelatin in tube
MSA • Selective • Differential • Substrate – Mannitol – Salt (7. 5%) • p. H = phenol red • Reaction – Growth – Fermentation

Nitrate Reduction • Inoculate with loop • Incubate • Additional solutions – Sulfanilic acid (A) – Naphthylamine (B) • (+) = Red – Nitrate to Nitrite • No color, add Zinc – (+) = not red – (-) = red

Citrate • Enzyme – Citrase • Substrate – Citrate • p. H – Bromthymol blue • Reaction – Keto acids • Oxaloacetic – Pyruvate • Acetic acid – CO 2 + Na. H 2 CO 3 – Prussian blue = +

Bile Esculin Agar (BEA) • Selective – Bile Salts • Differential – Esculin (CH 2 O) – Fe-NH 3 -citrate • Reaction – Growth in bile – Hydrolyze esculin • Esculetin-Iron Rxn • Black precipitate

Results • Exoenzymes – Starch (amylase, maltase) – Lipid (lipase) – Proteins (Casease, protease) – Collagen (Gelatinase) • Reaction – (+) = clearing – (-) = no clearing

Starch Hydrolysis
Lipid Hydrolysis
Protein Hydrolysis

Gelatin (Collagen) Hydrolysis

BEA and Citrate Results + Bile Esculin + Citrate

Hydrolysis Results Summary casein Gelatin lipid Starch
- Slides: 21